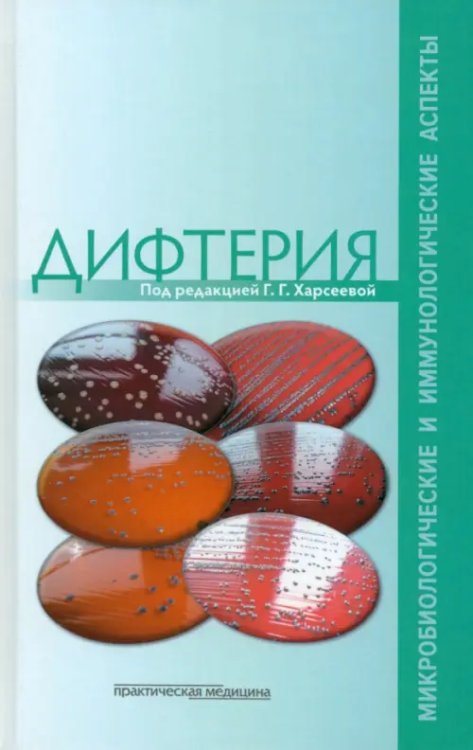
Дифтерия. Микробиологические и иммунологические аспекты

Аннотация: Дифтерия. Микробиологические и иммунологические аспекты
В издании отражены современные представления о свойствах возбудителя дифтерии, факторах его патогенности и их роли в патогенезе заболевания, механизмах формирования противодифтерийного постинфекционного и поствакцинального иммунитета, клинической и эпидемиологической характеристике современной дифтерии, методах ее лабораторной диагностики и питательных средах, используемых для культивирования возбудителя. Приведены данные об основных биологических свойствах и чувствительности к антибактериальным препаратам недифтерийных коринебактерий.
Книга рассчитана на широкий круг врачей - бактериологов, инфекционистов, педиатров, иммунологов, эпидемиологов и других специалистов.
| Автор/составитель | Харсеева Галина Георгиевна, Алутина Эльвира Львовна, Гасретова Татьяна Дмитриевна, Дятлов Иван Алексеевич |
| Год выпуска | 2014 |
| ISBN | 978-5-98811-277-8 |
| Производитель | Практическая медицина |
| Издательство | Практическая медицина |
| Количество томов | 1 |
| Количество страниц | 241 |
| Переплет | Твёрдый переплёт |
| Размеры | 210x135x16 мм |
| Цвет | Зелёный |
| Тип бумаги | офсетная (60-220 г/м2) |
| Наличие иллюстраций | рисунки |
| Тип иллюстраций | черно-белые |
| Формат | 84x108/32 (130x200 мм) |
| Тираж | 1000 |
| Стандарт | 16 |
| Вес | 310 |
| Язык | русский |
Бесплатная Доставка по Европе (EU)*
*Для заказов свыше 40, - евро Подробнее
Дифтерия. Микробиологические и иммунологические аспекты
- Производитель: Практическая медицина
- Модель: MYSH1834843
- ISBN: 978-5-98811-277-8
- Наличие:
-
Срок доставки: 21 день
- (1 оценка)